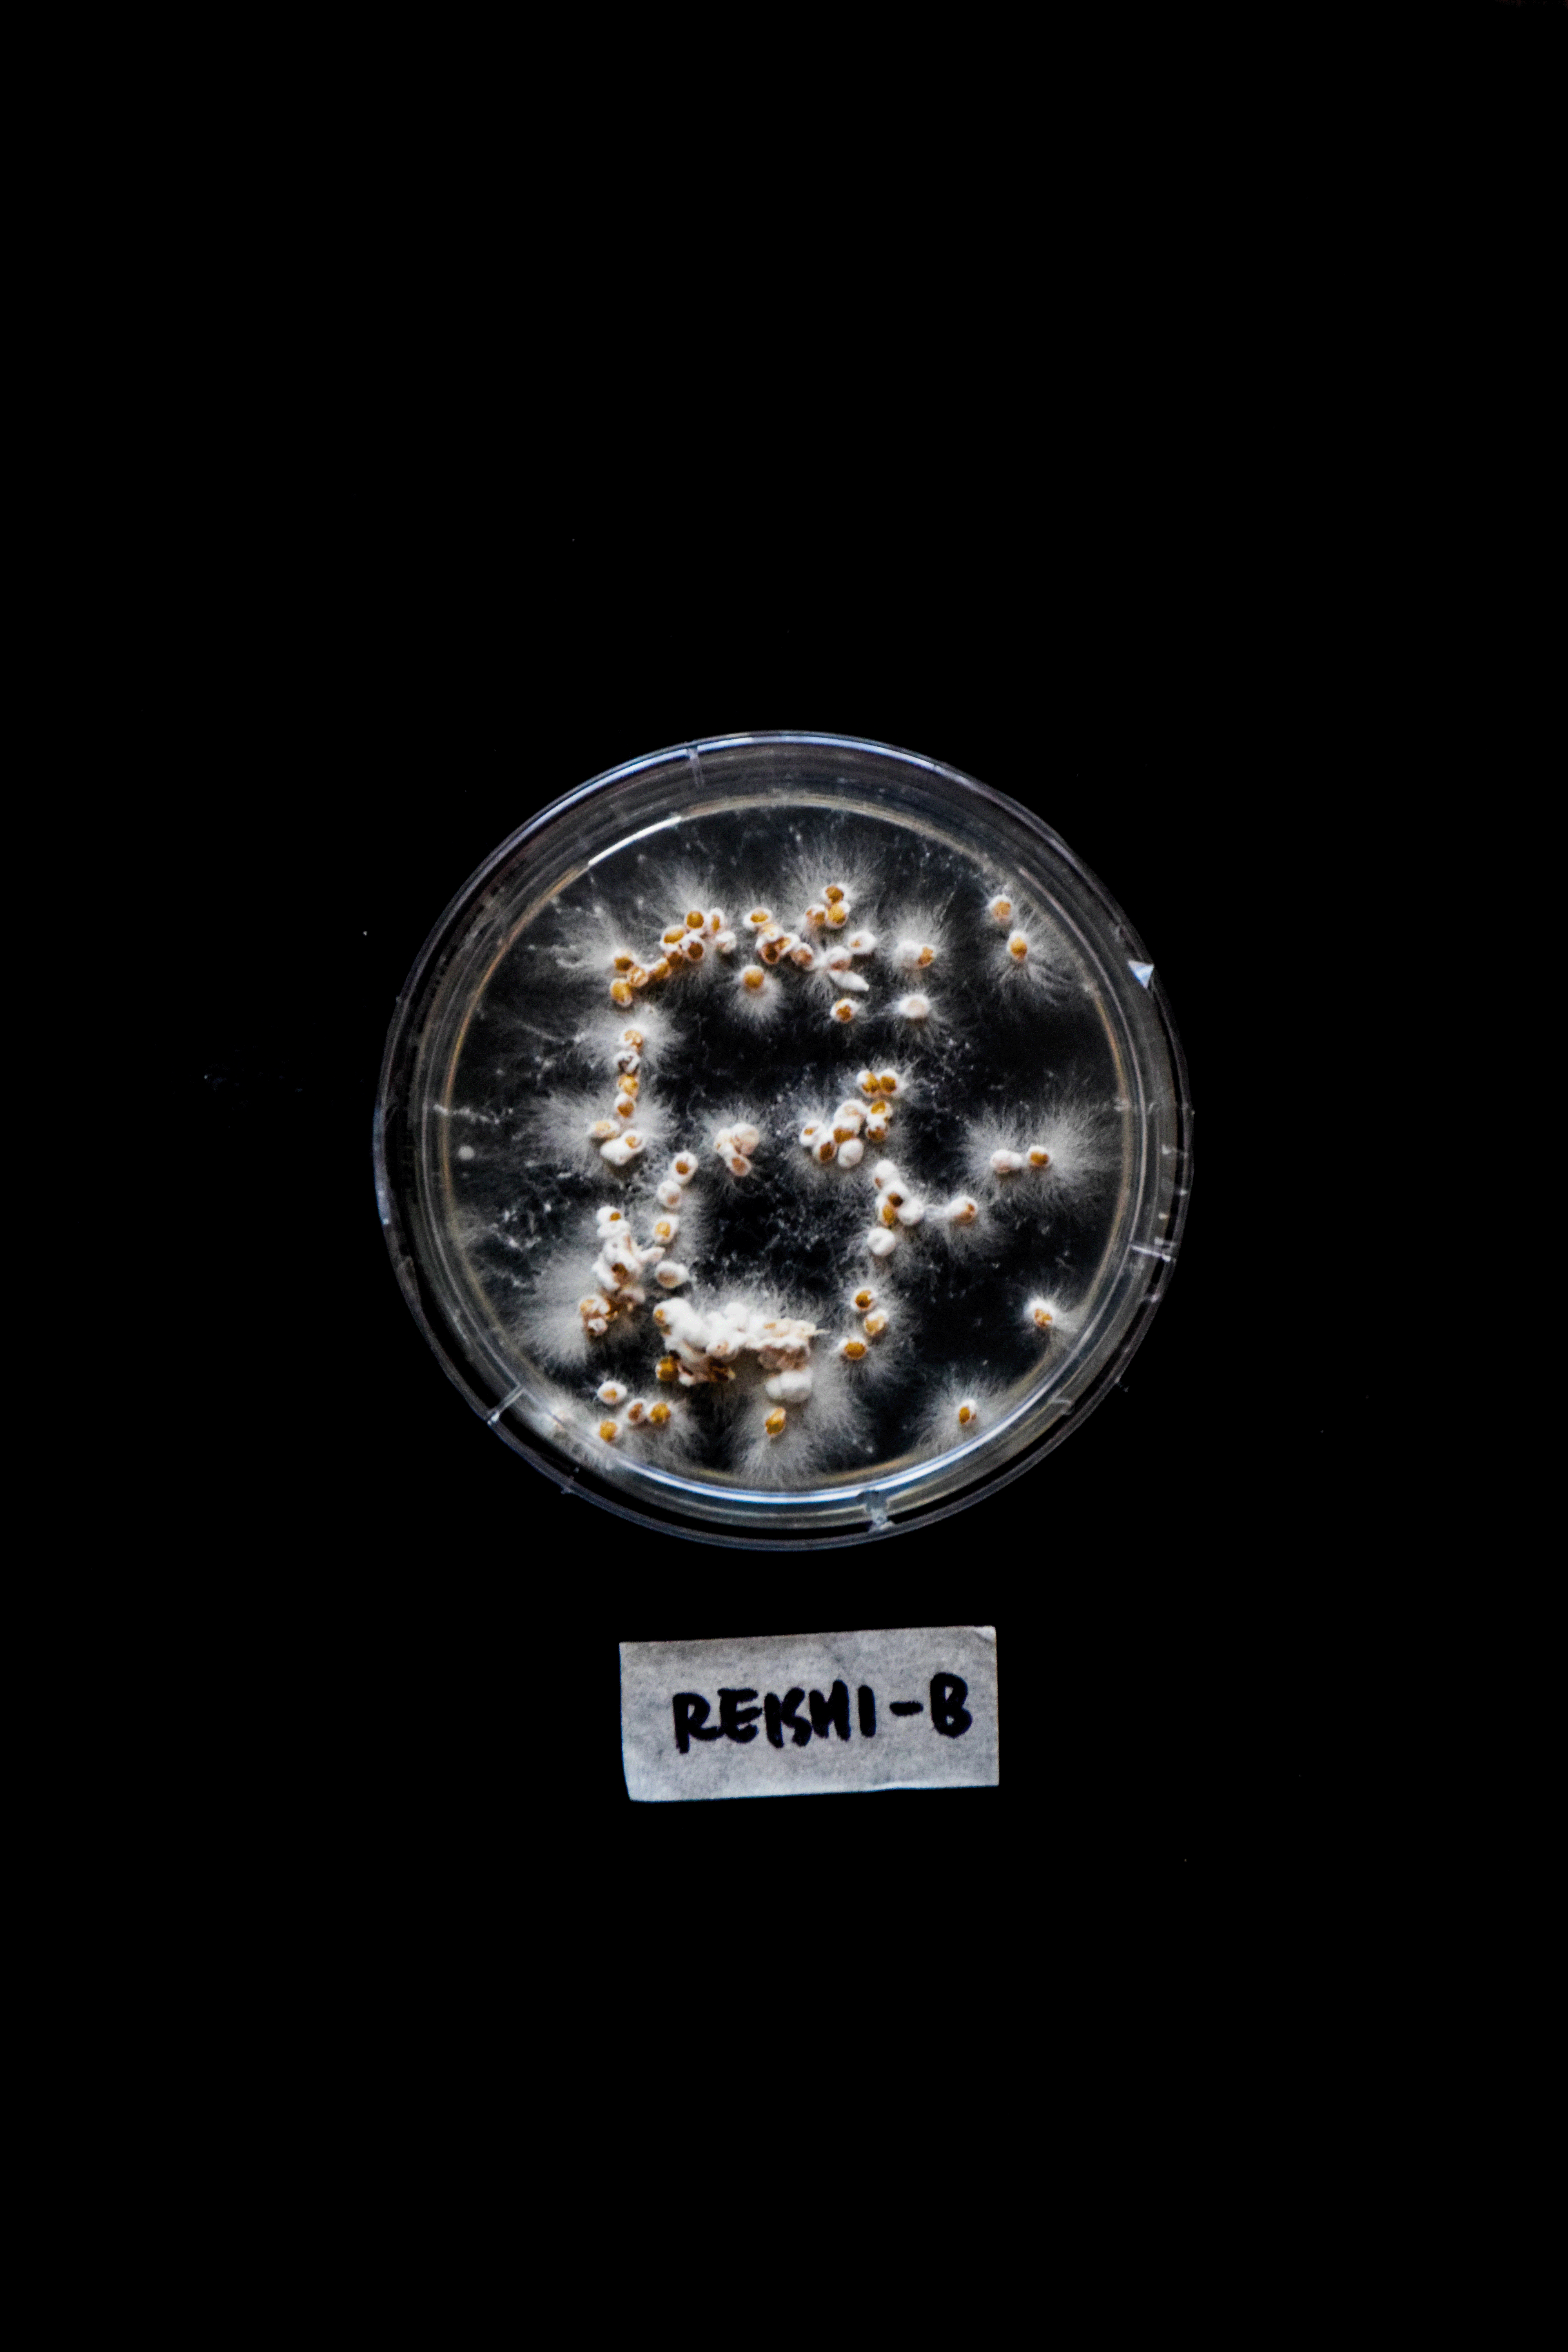
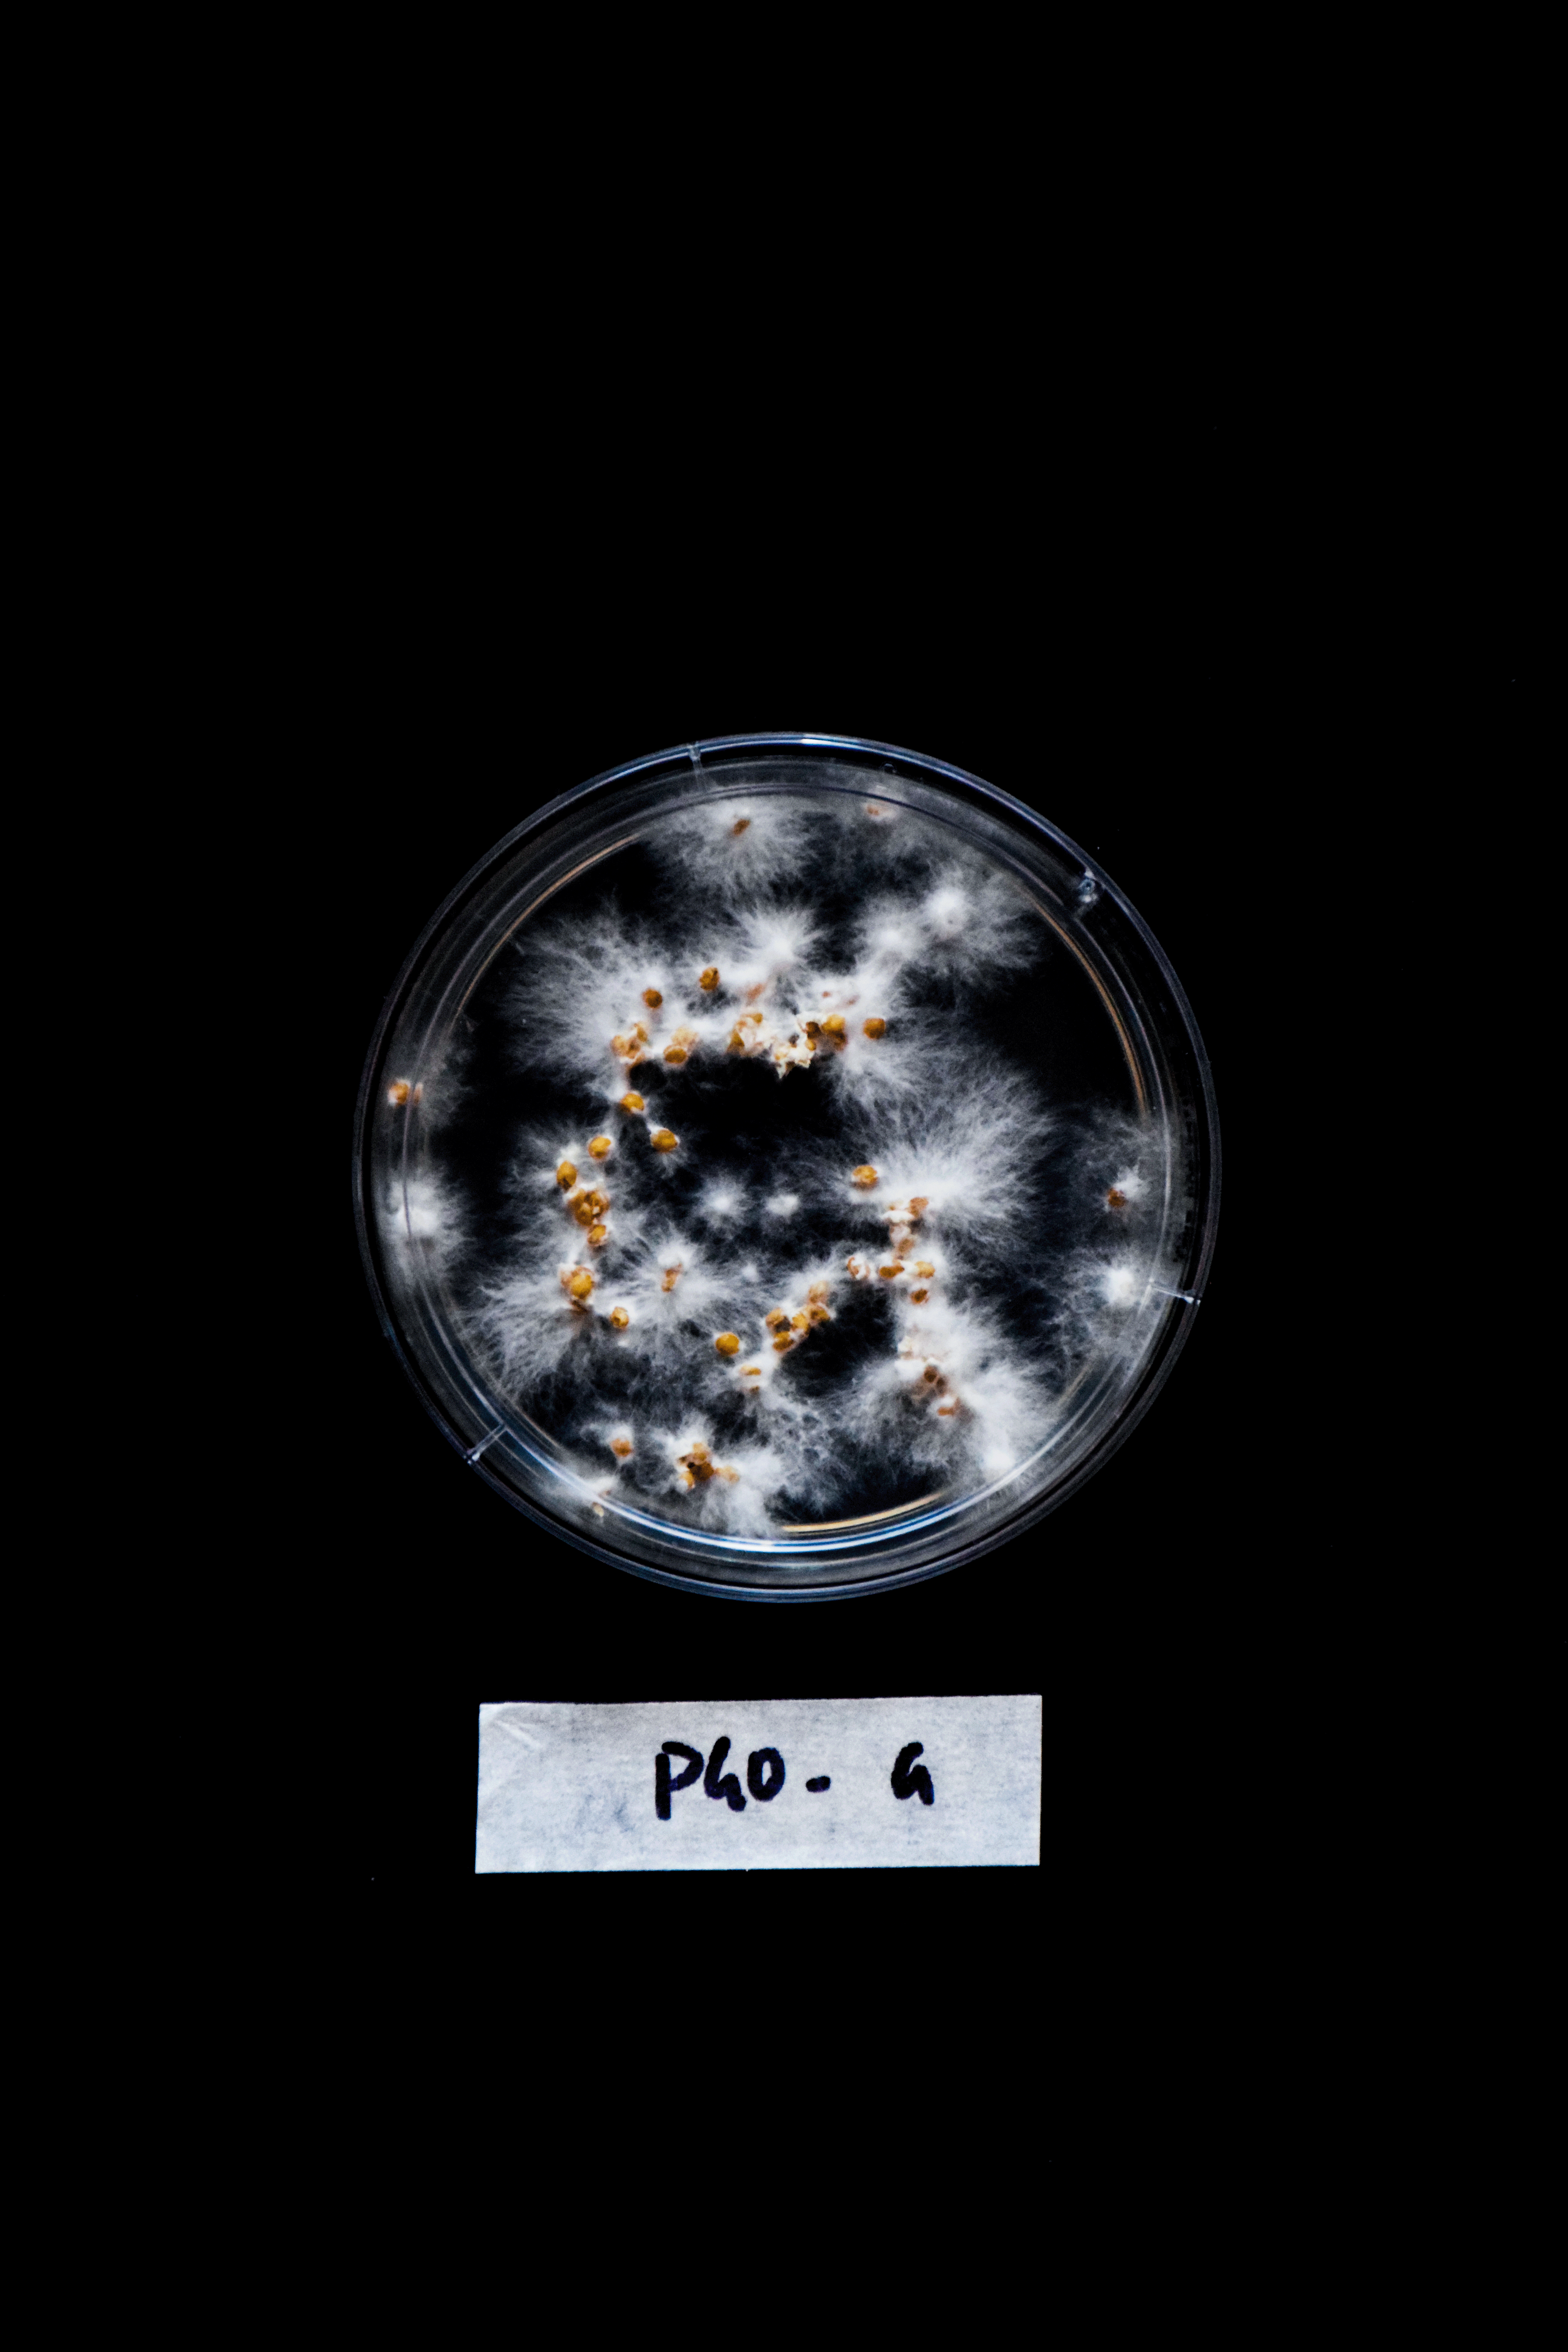
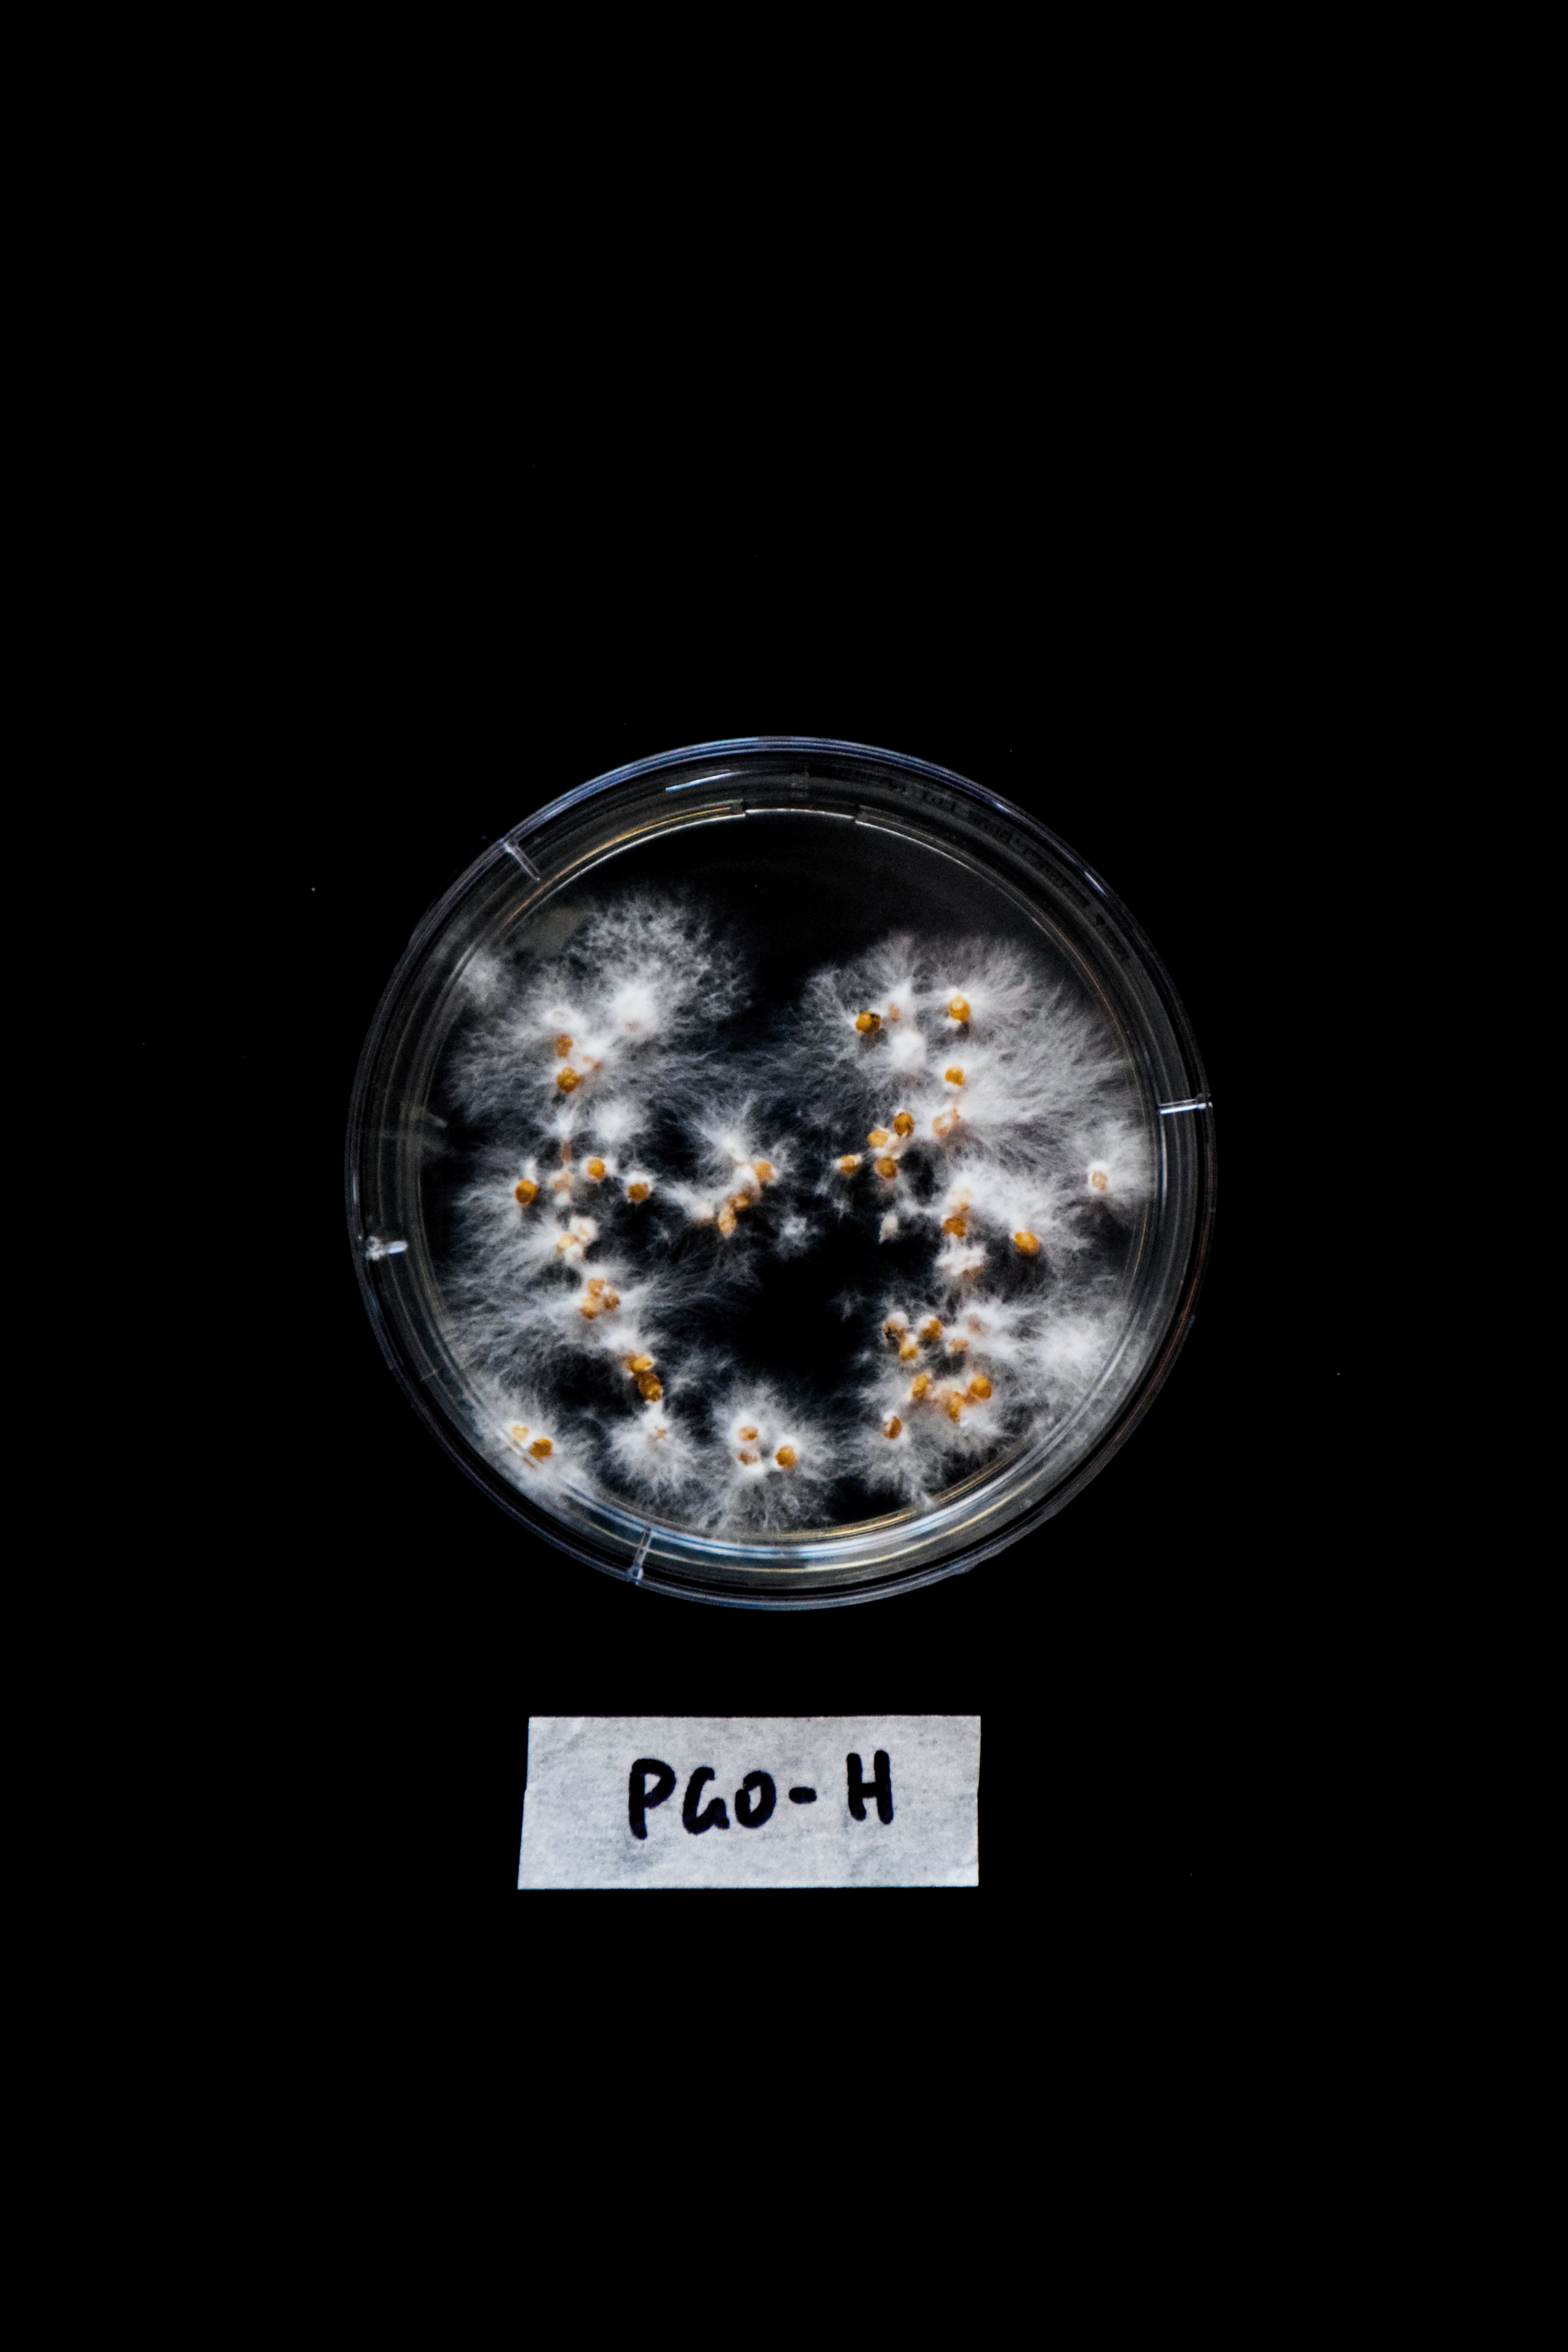
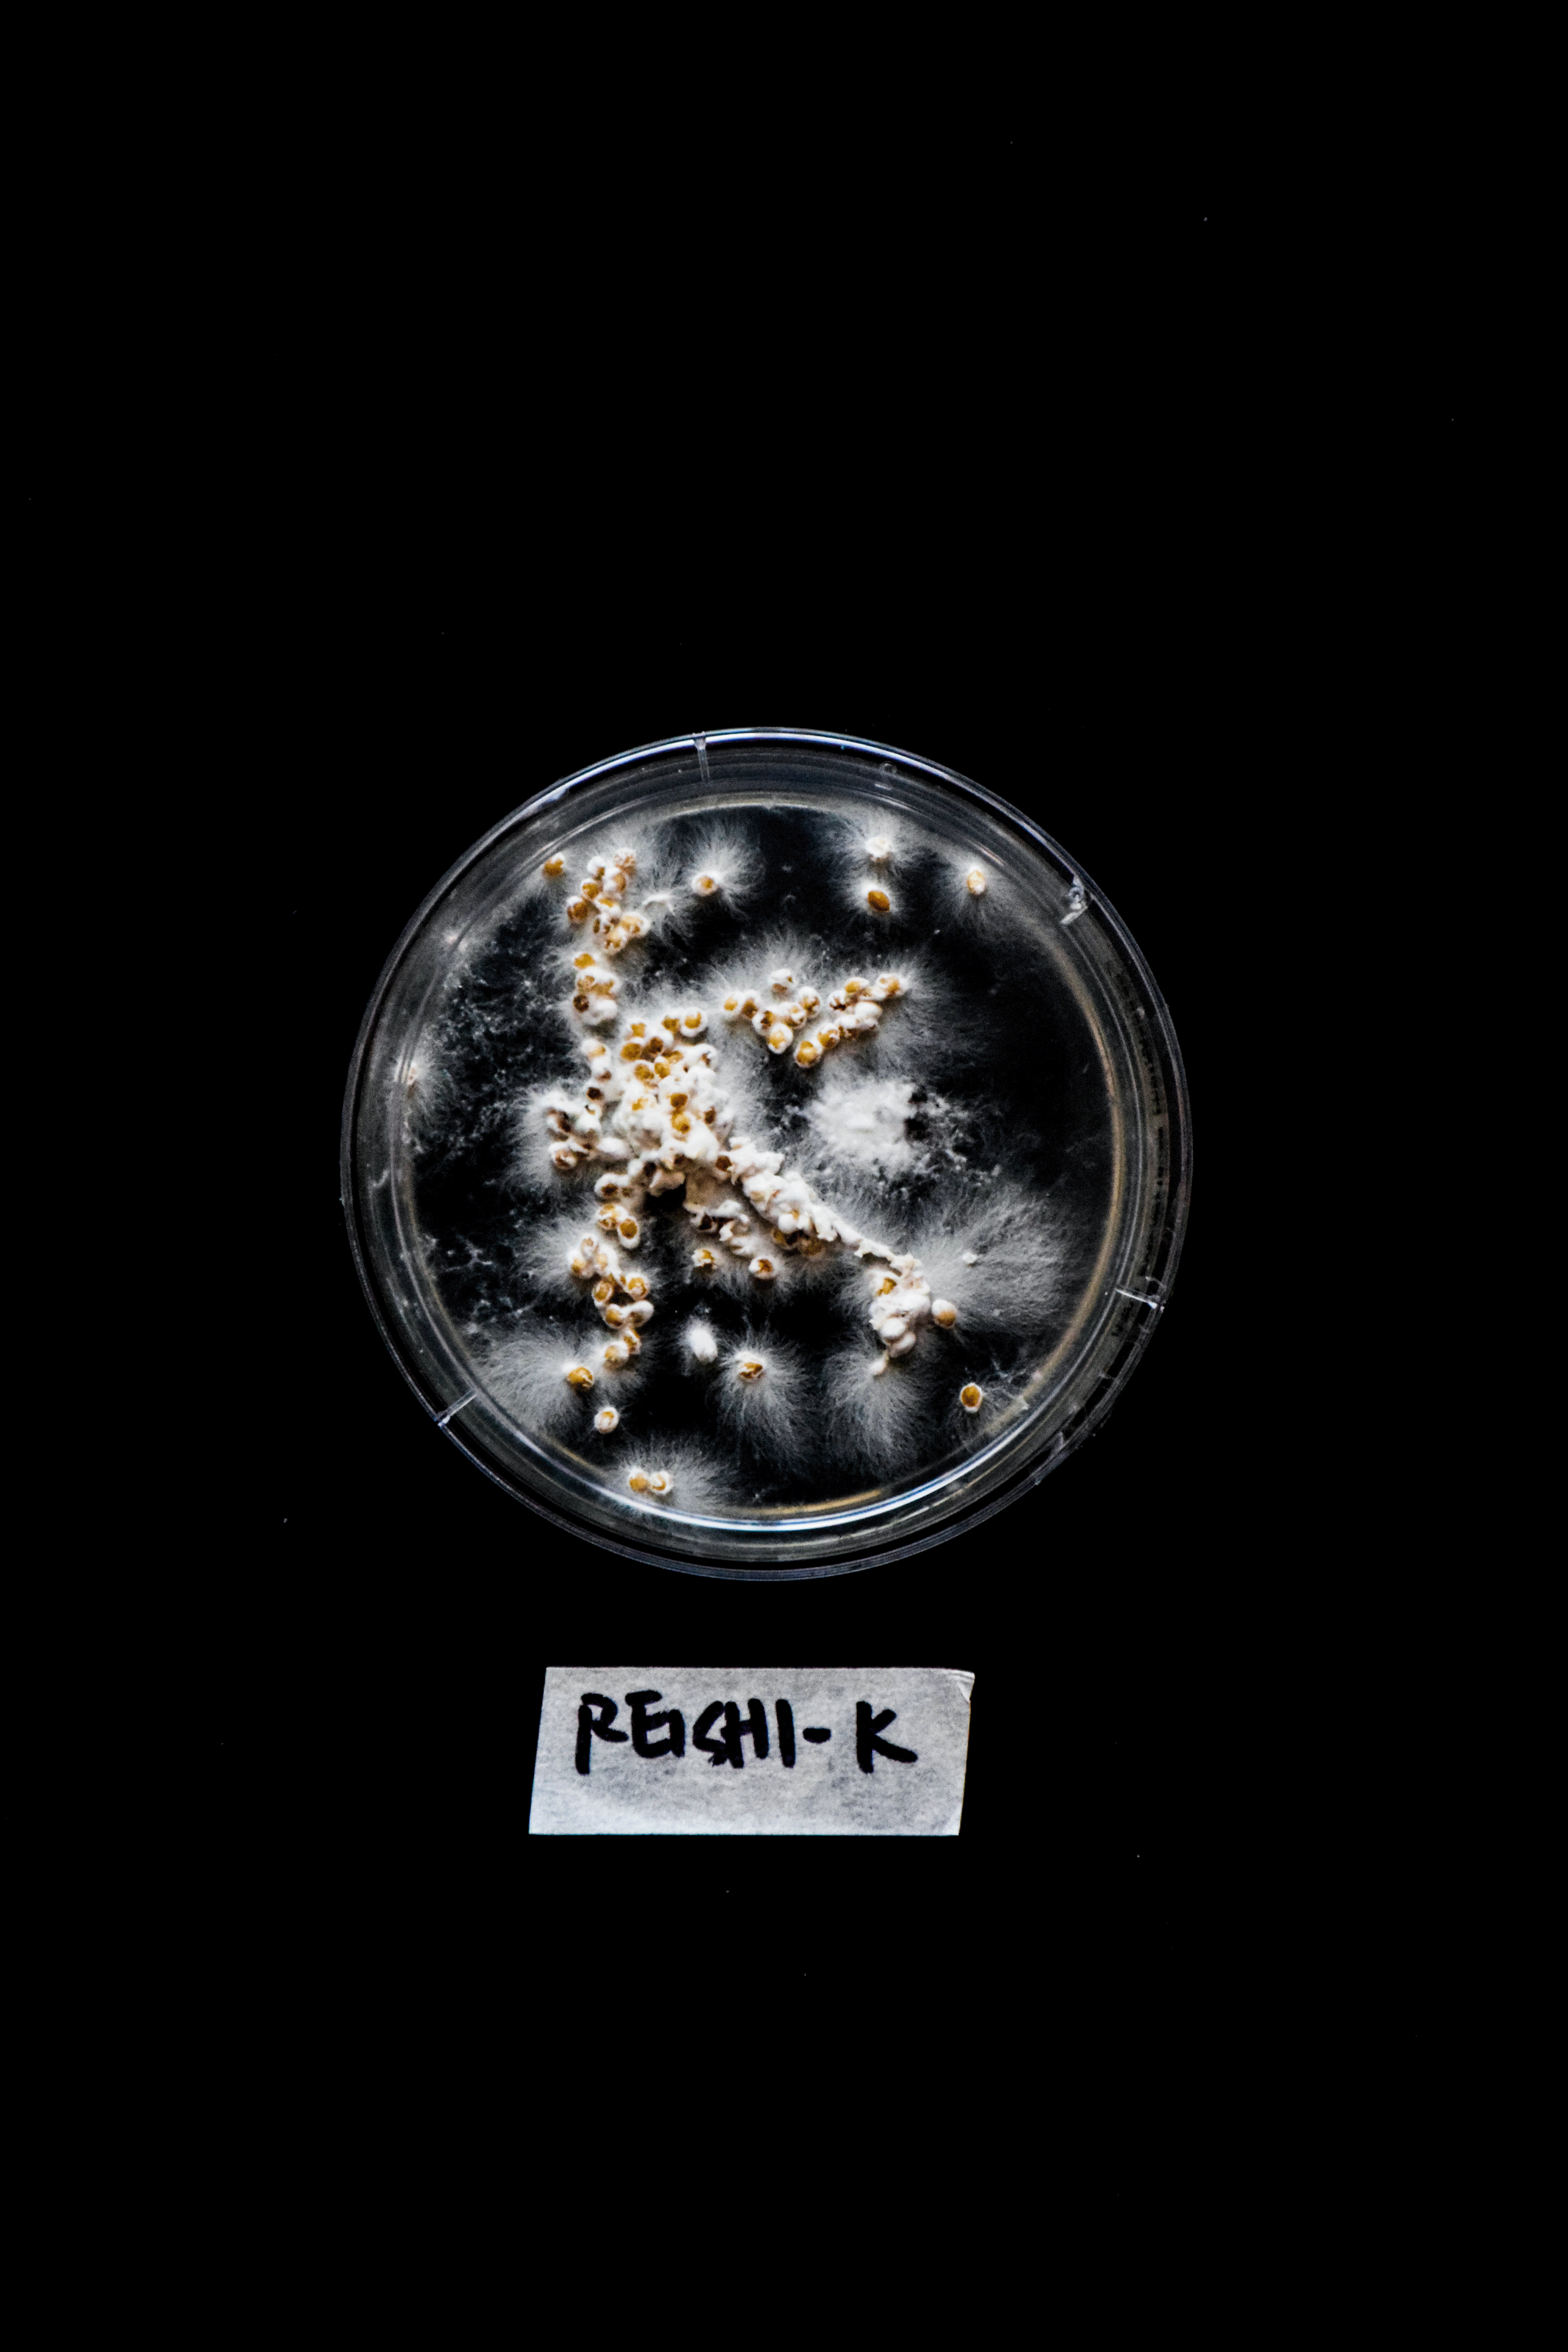
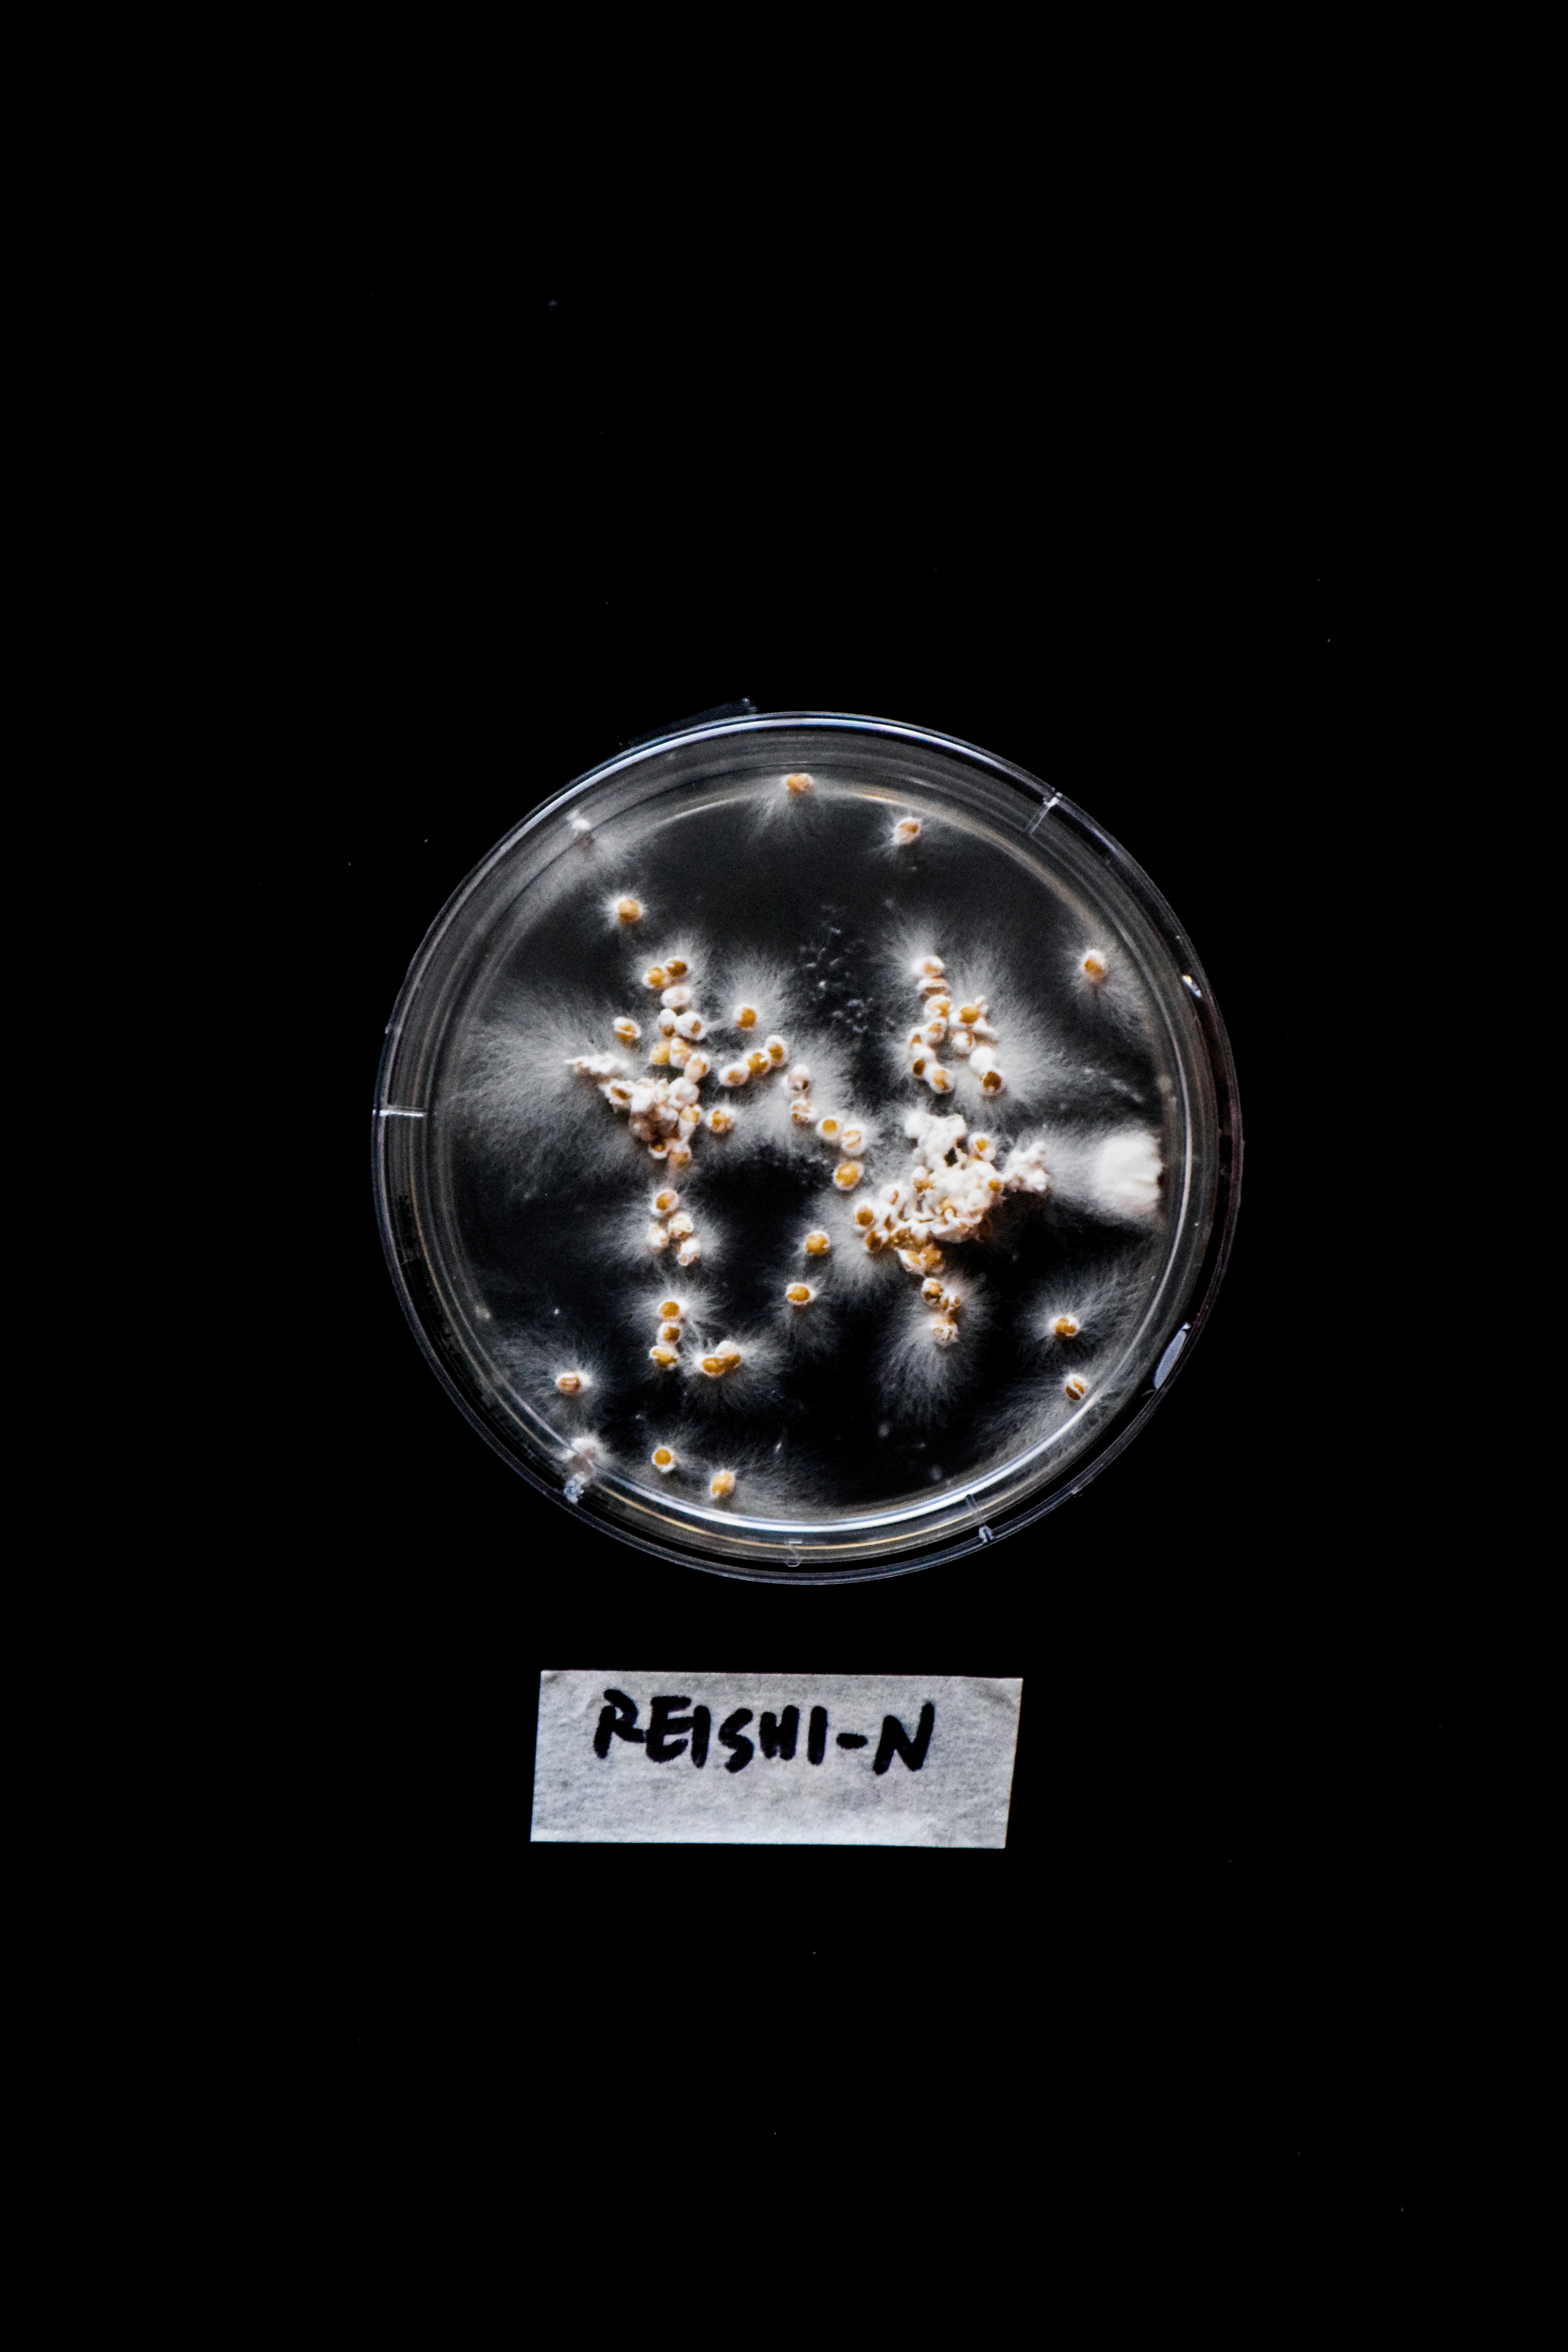
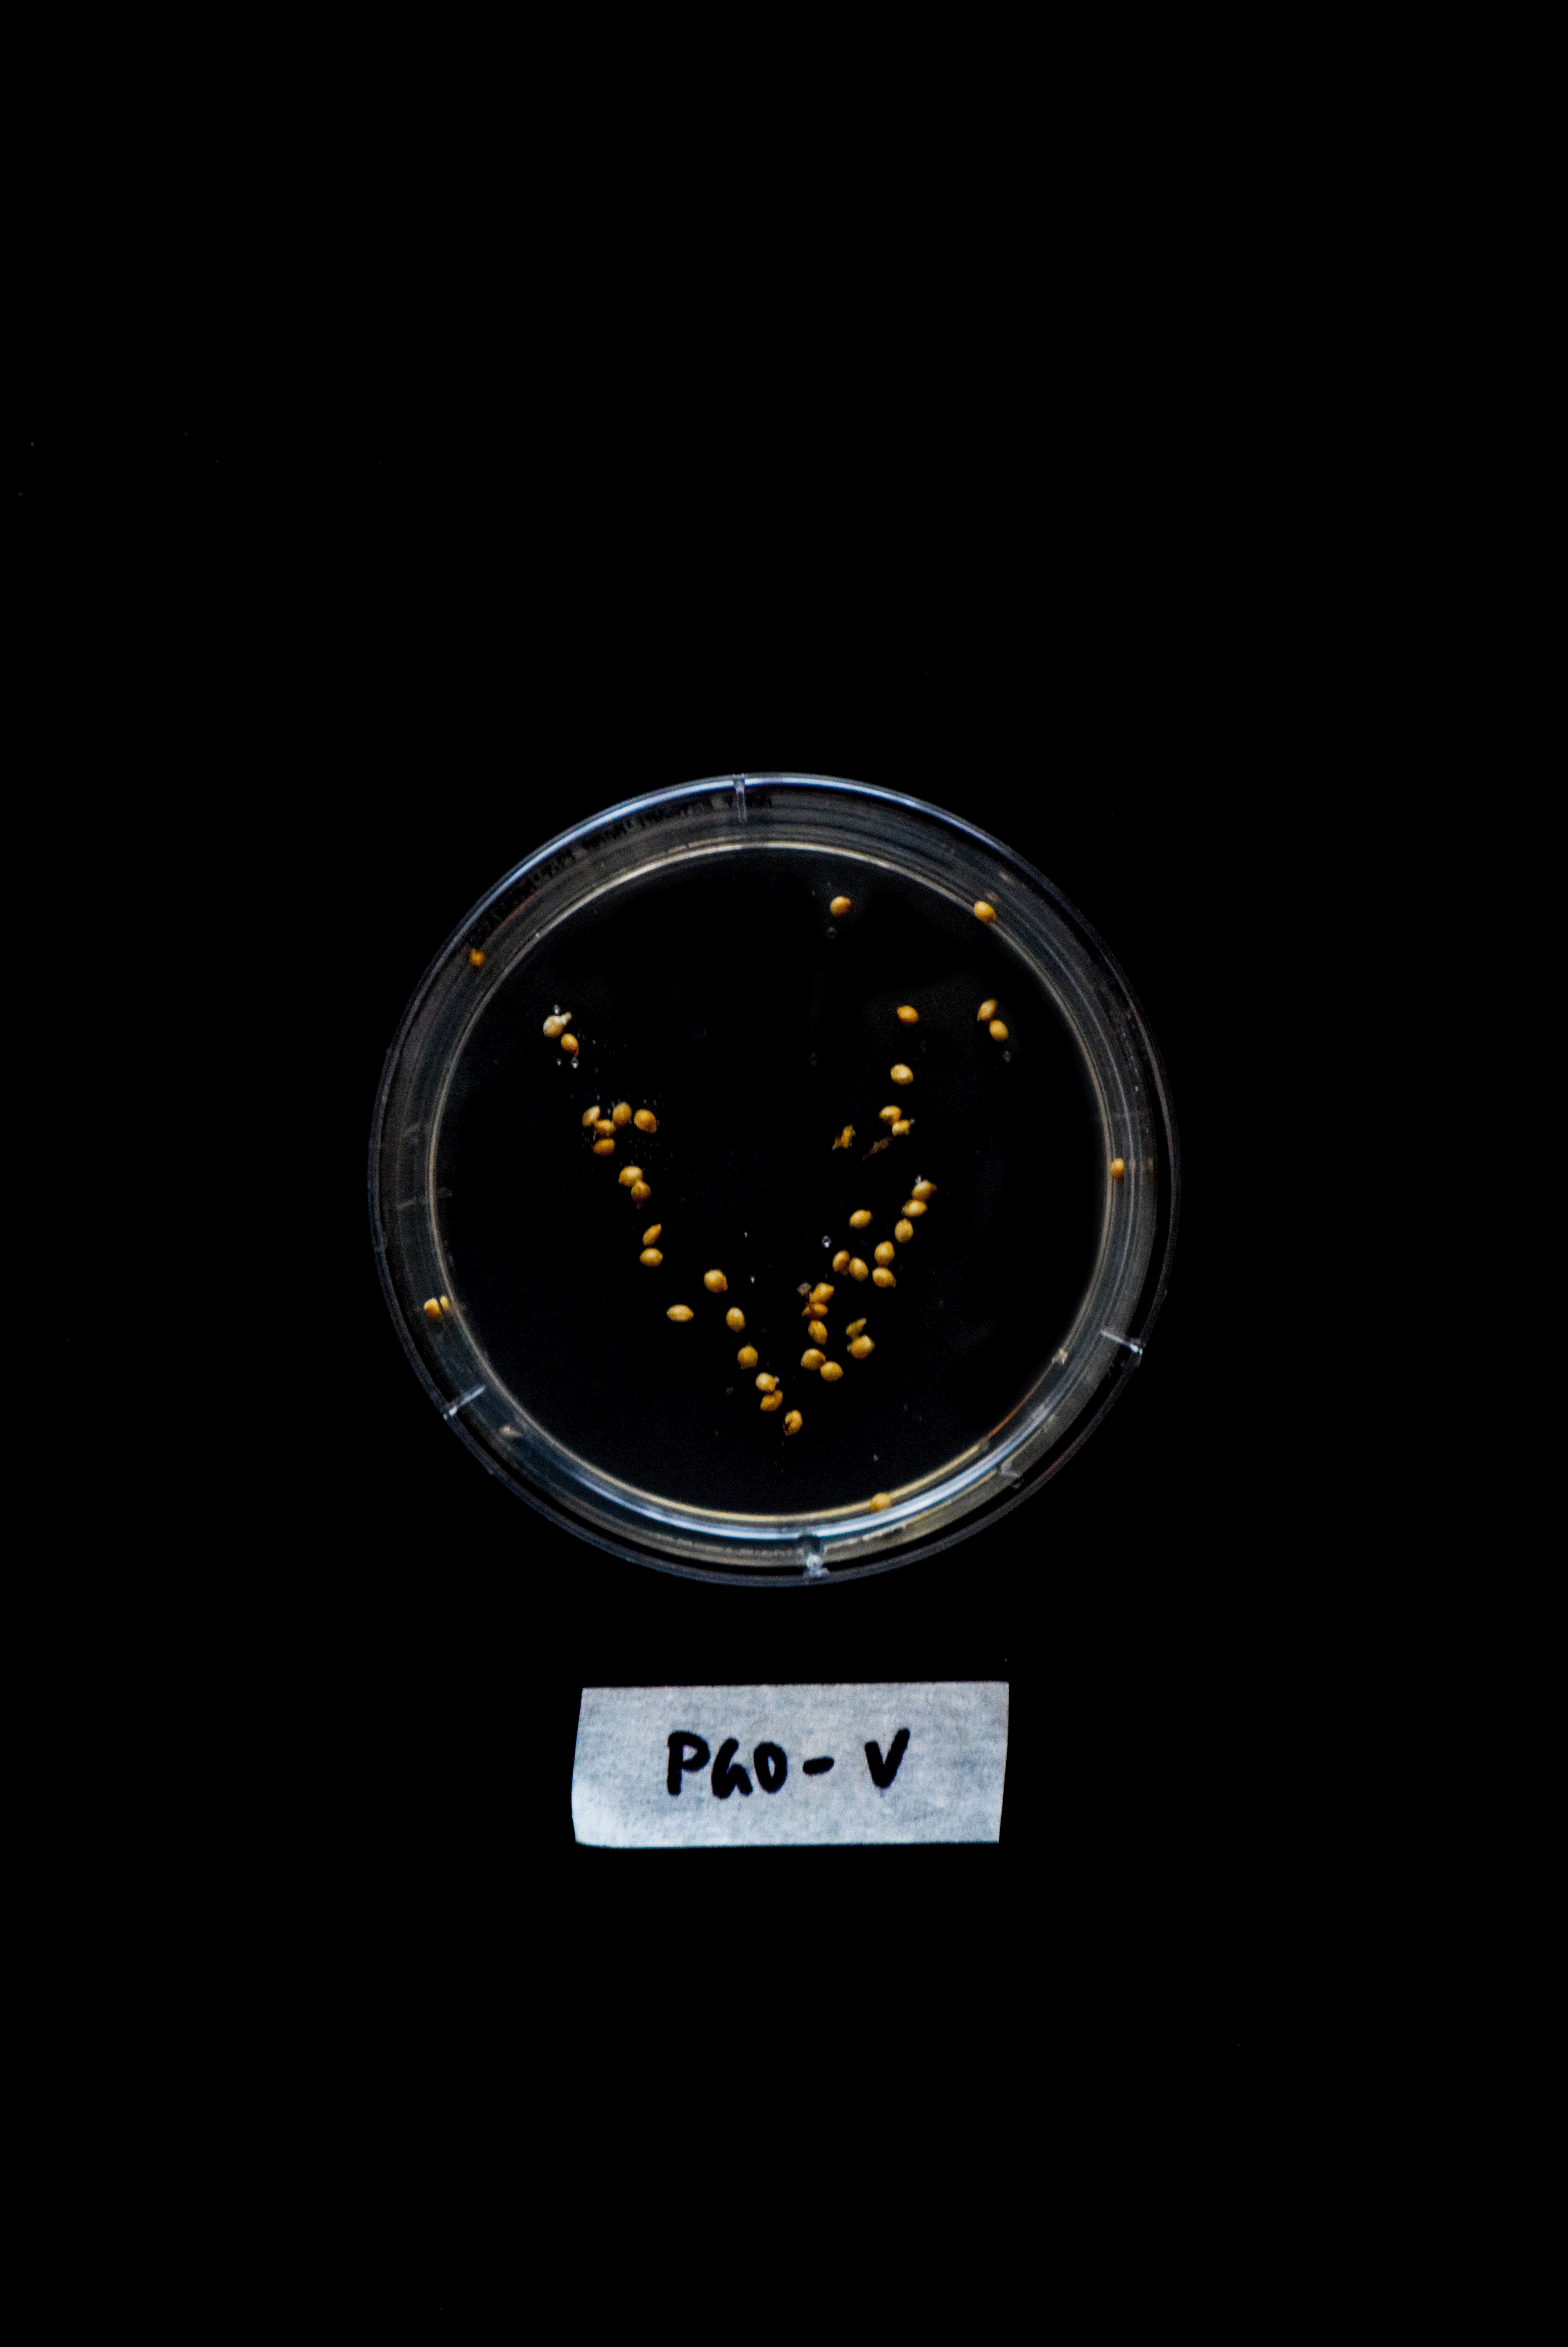
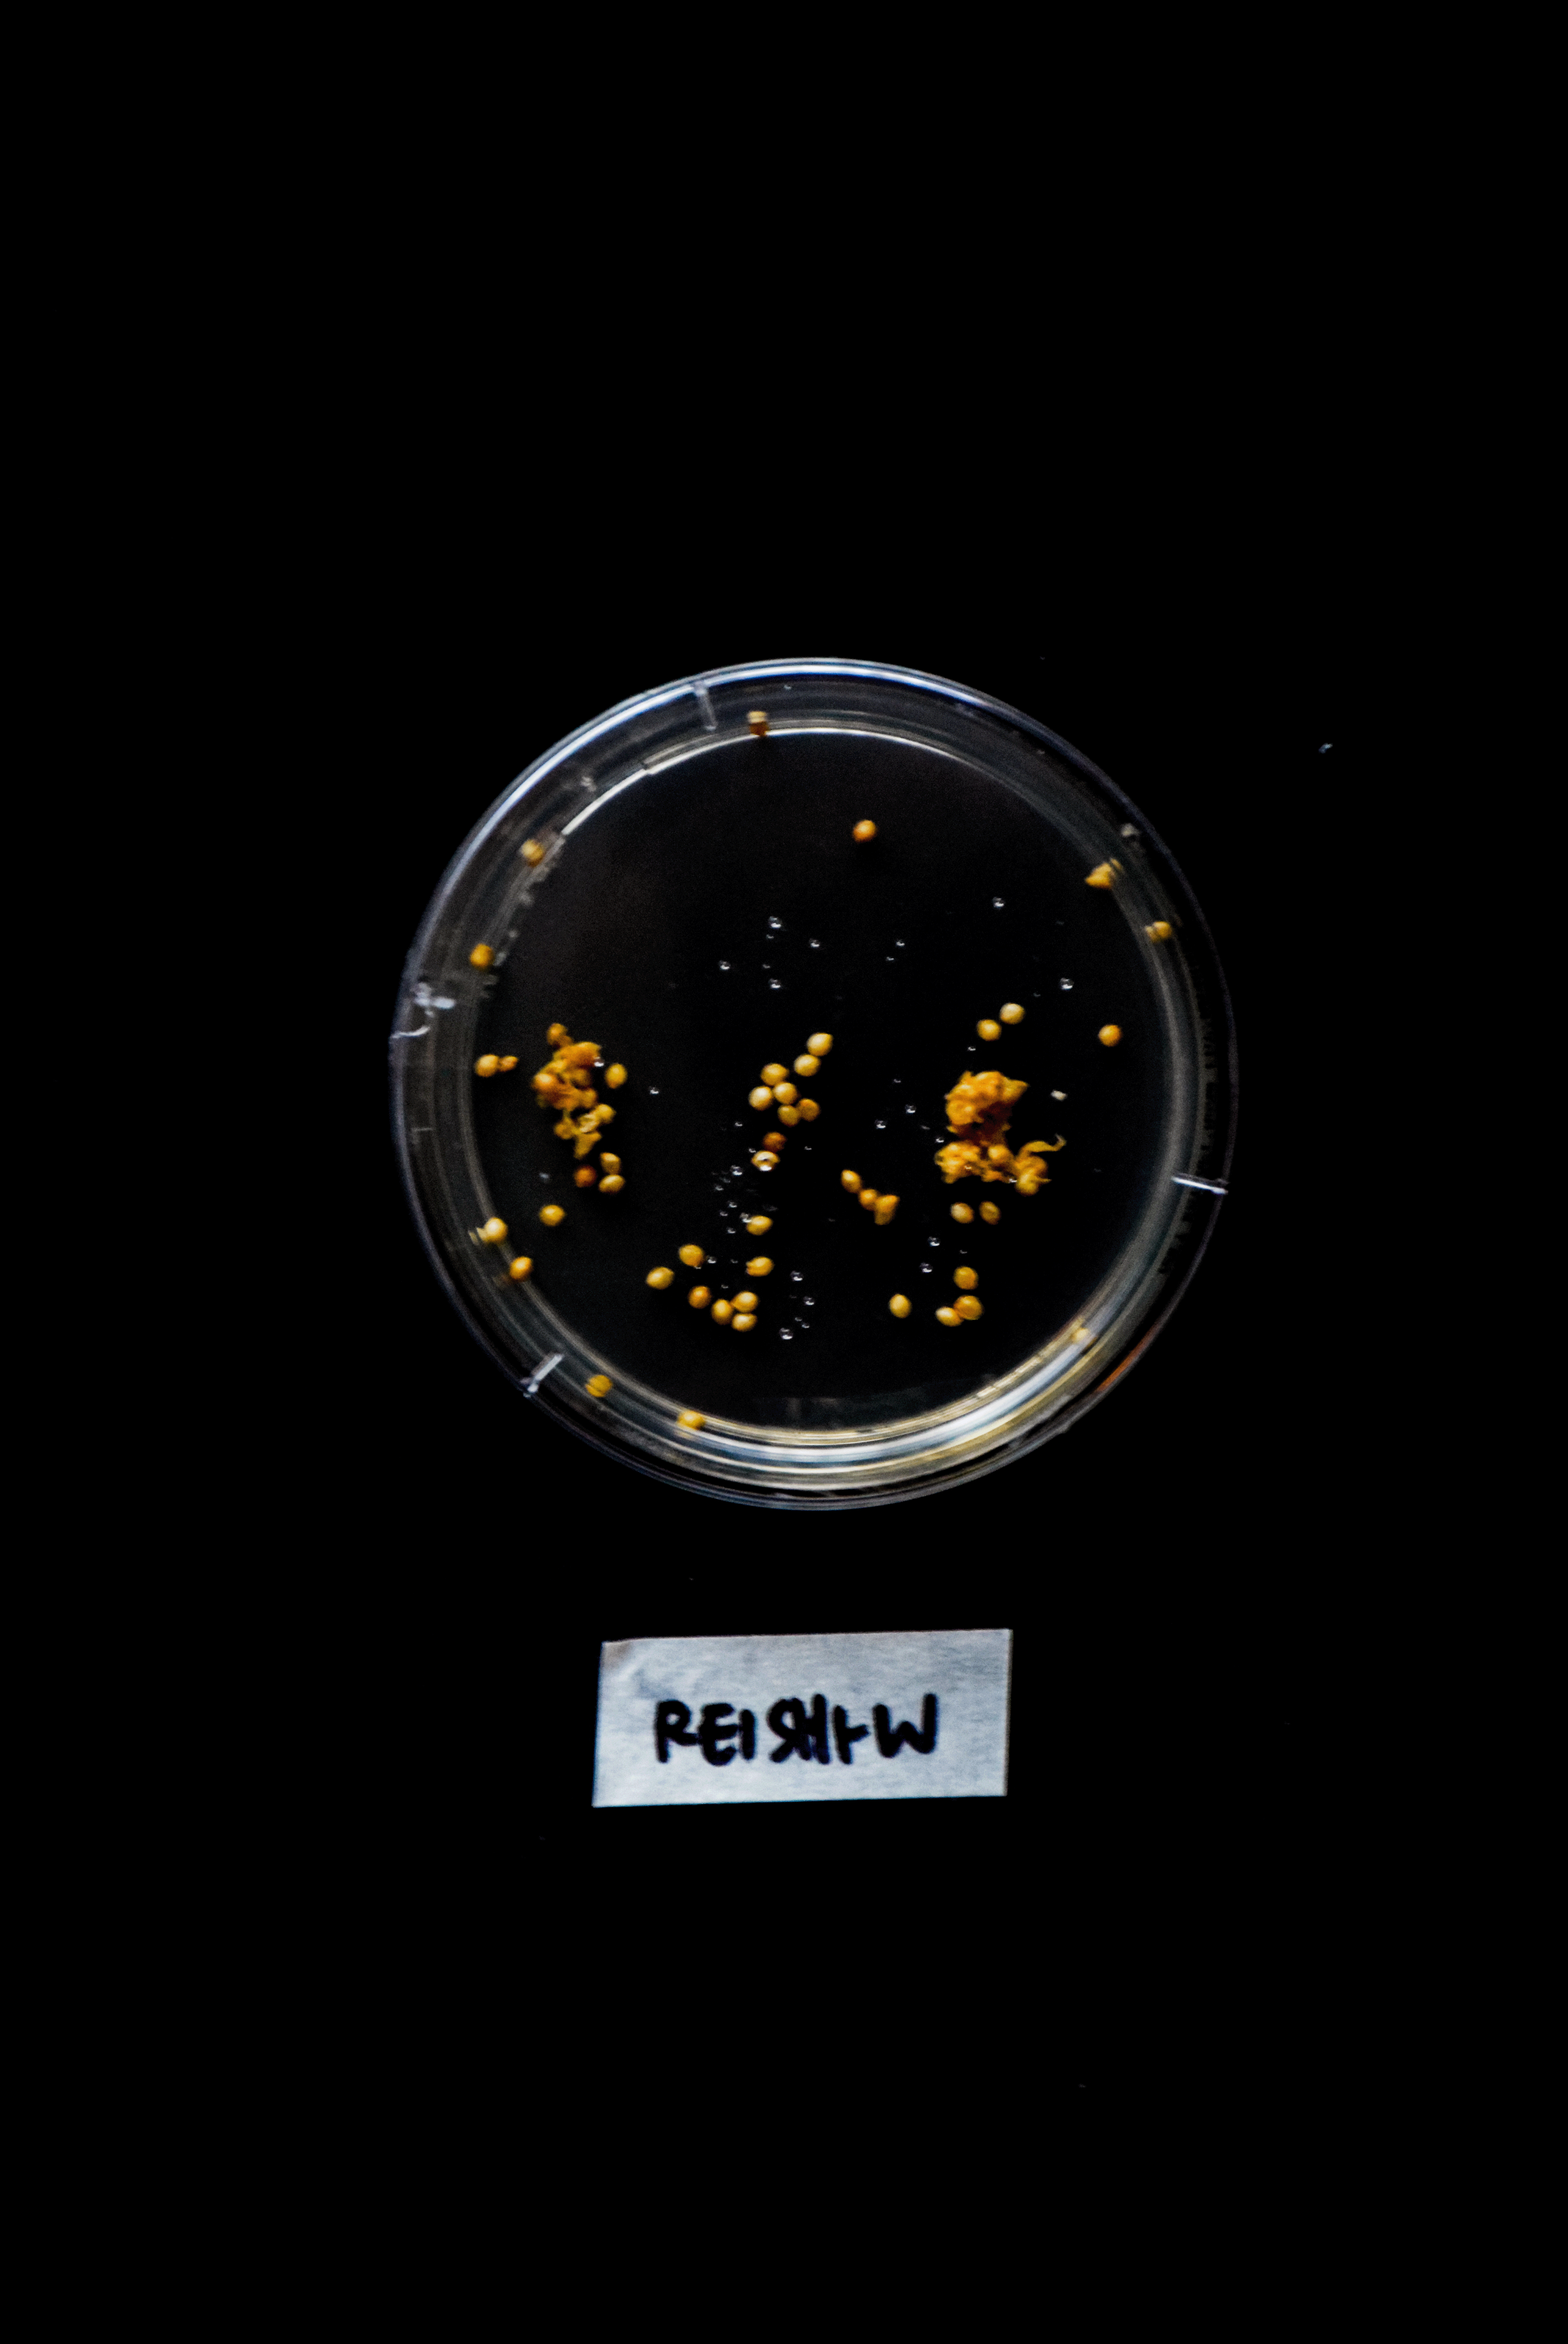
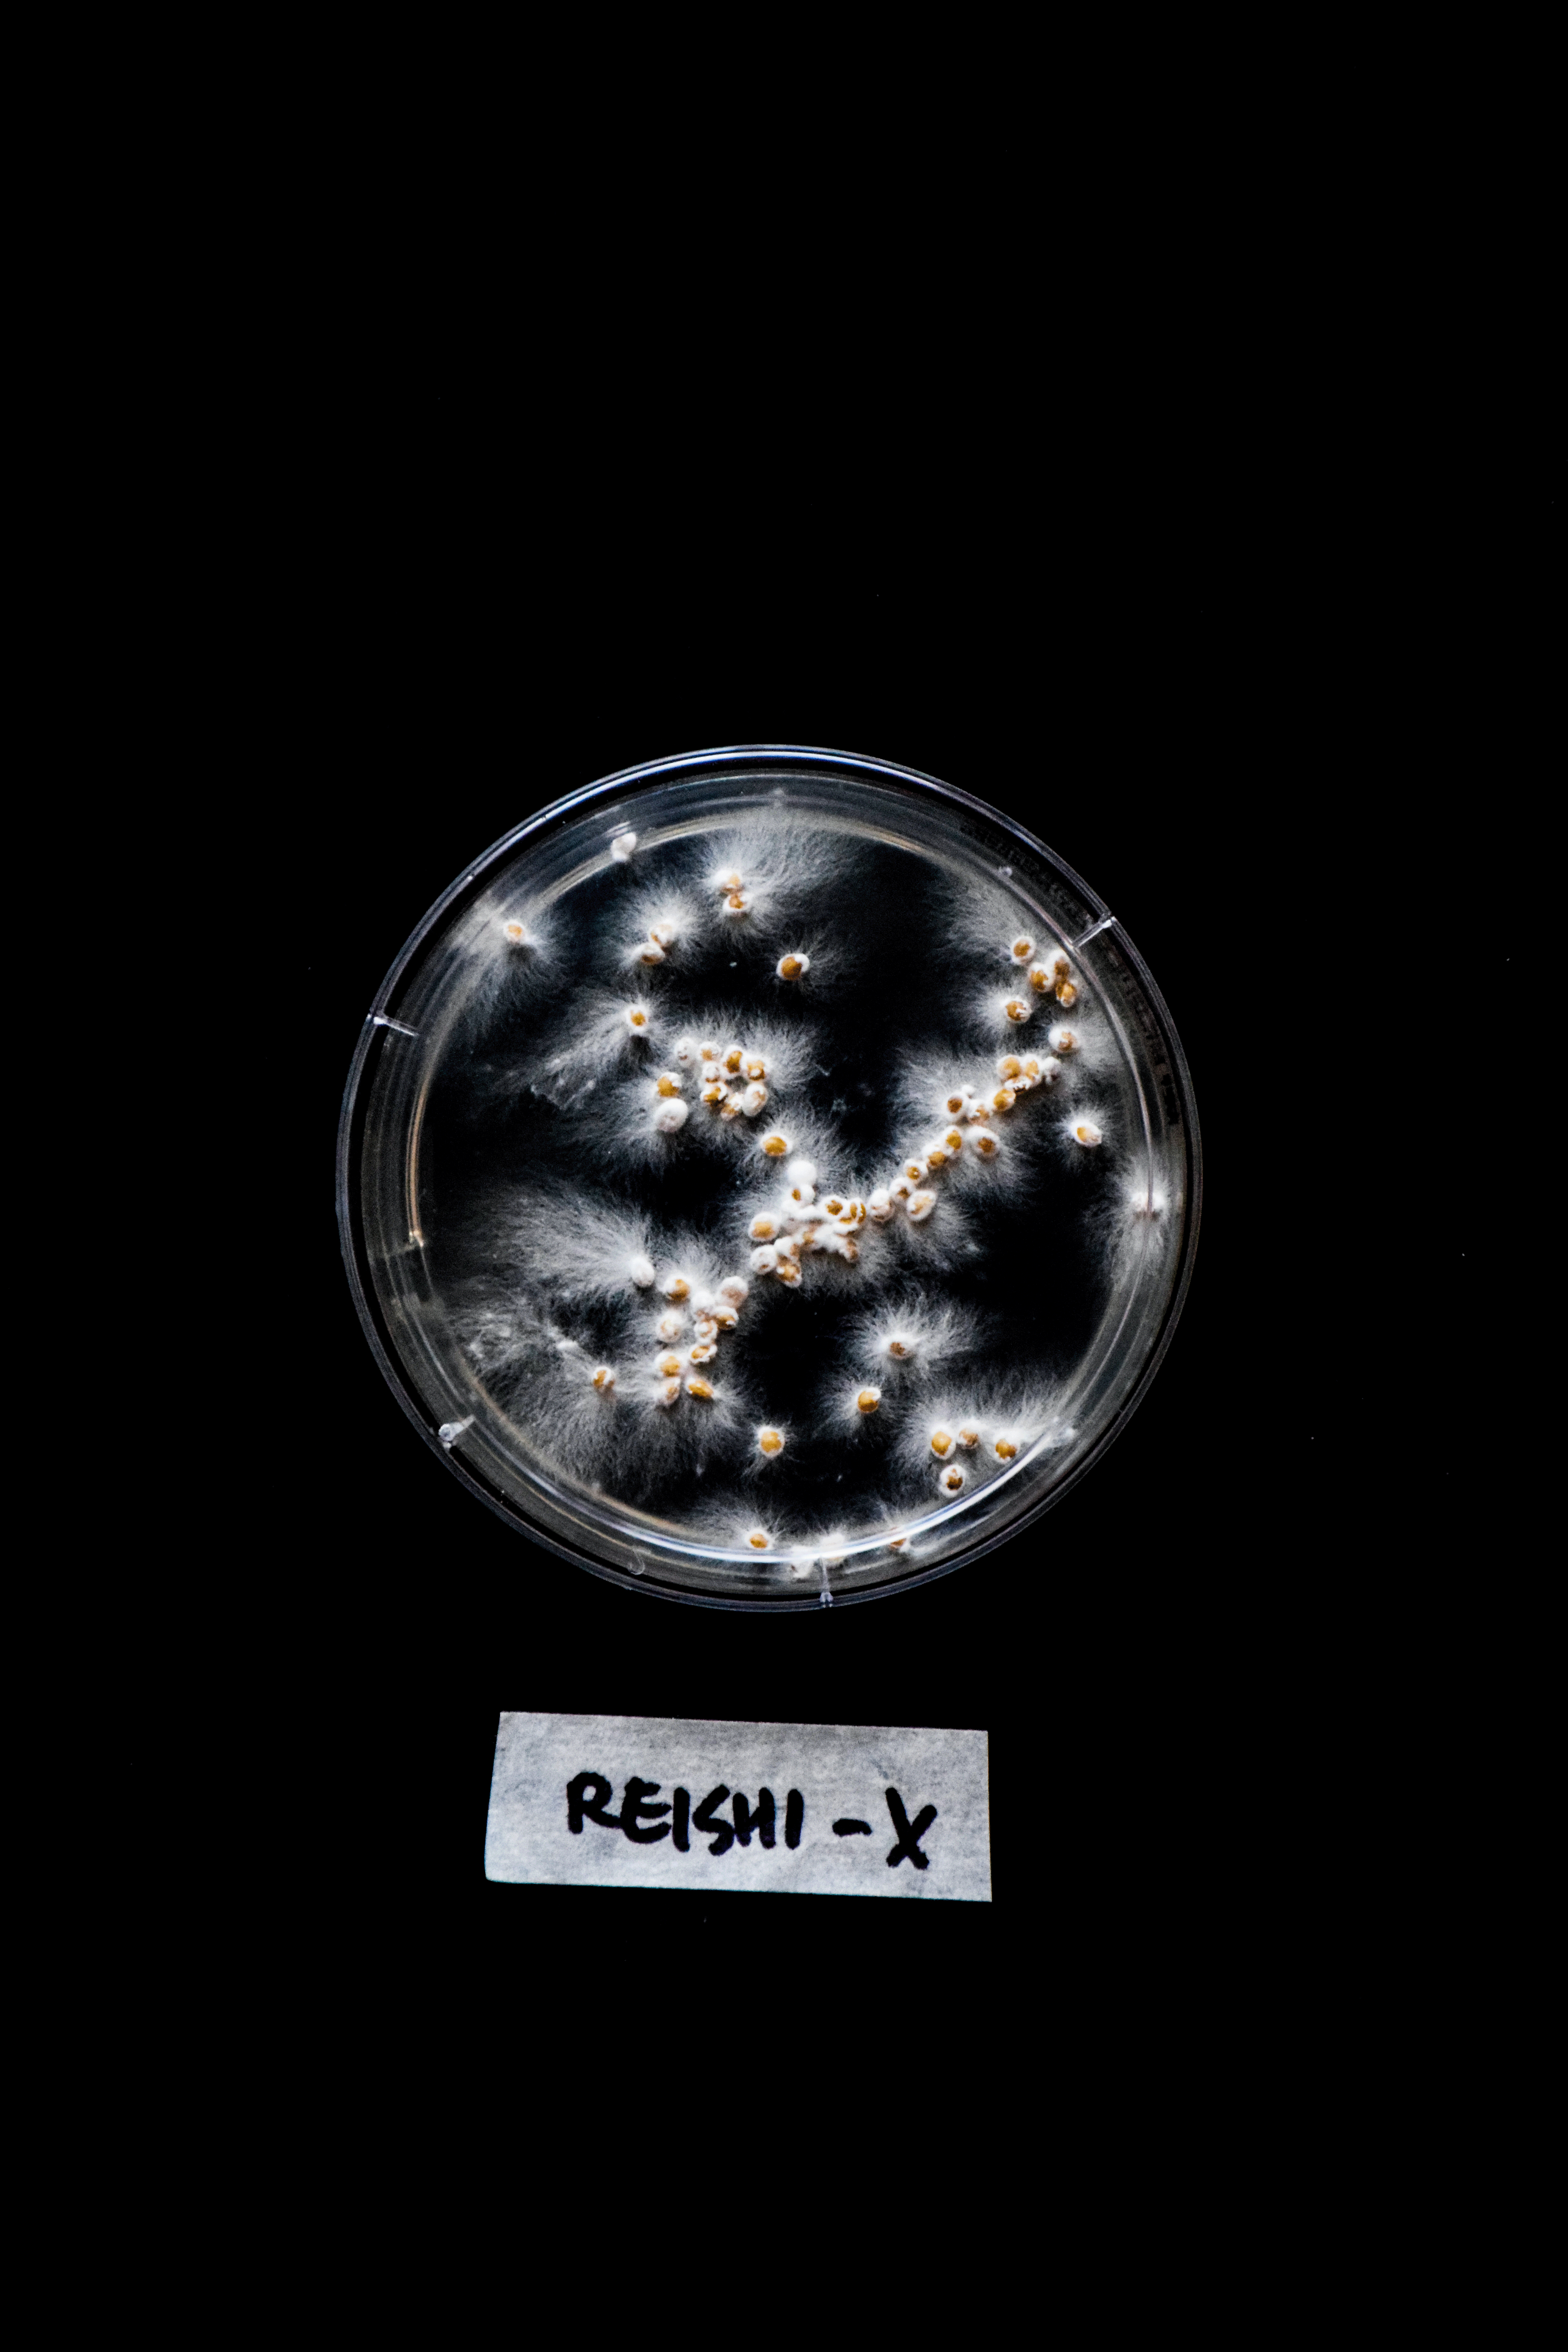

Selected Photographs from Experiment 1B
Alphabet Archive (1B)
Uppercase letters on DAY 1 and DAY 7 respectively
(A)


(B)

(C)


(D)


(E)


(F)


(G)

(H)

(I)


(J)


(K)

(L)


(M)


(N)

(O)


(P)


(Q)


(R)


(S)


(T)


(U)


(V)

(W)

(X)

(Y)


(Z)

